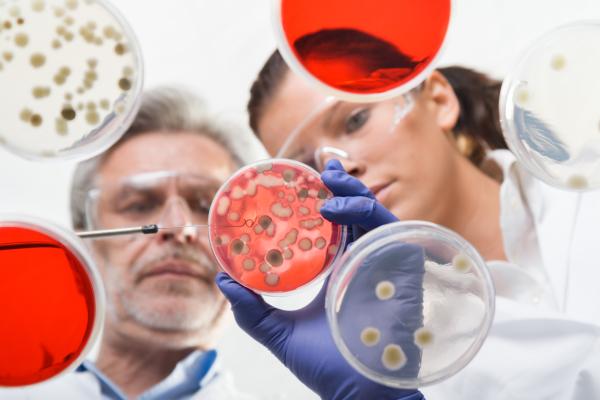
Biología celular: qué es, aplicaciones e importancia - Qué es la biología celular y qué estudia

Biología celular: qué es, aplicaciones e importancia


La Teoría Celular atribuye a la célula el papel de unidad fundamental de vida y constituye uno de los principales pilares de la biología. Pero la célula no estaba en el ideario del ser humano hasta que una serie de estudiosos del siglo XVII llevaron a cabo trabajos de investigación sobre ella. Estos hombres estaban creando sin saberlo una nueva disciplina de la biología que se sitúa hoy como una de las más prolíficas e importantes y que se conoce como biología celular. Si esto te ha parecido interesante y quieres saber más, te invitamos a leer este artículo de BIOenciclopedia acerca de qué es la biología celular, sus aplicaciones e importancia.
Qué es la biología celular y qué estudia
La biología celular es una disciplina científica que pertenece a la biología y cuyo objeto de estudio es lo que se considera la unidad elemental de la vida, es decir, la célula en sí misma, así como sus intercambios de energía y materia con su entorno, sus sistemas de comunicación intra e intercelulares. En otras palabras, la biología celular estudia la naturaleza y comportamiento de las células. También se conoce como citología, aunque es un término cada vez más en desuso, pero conviene conocerlo porque se encuentra frecuentemente en artículos de índole sanitaria.
Comprende tanto el estudio de las células eucariotas como procariotas, ya que ambos tipos comparten el mismo nivel de organización celular. Algunos de los temas más frecuentes de estudio son la regulación celular, las estructuras que componen las células, sus sistemas de señalización, su ciclo vital y su desarrollo.
Asociada a la biología celular se encuentran técnicas de laboratorio, metodologías e instrumentación común a otras disciplinas como, por ejemplo, las tinciones celulares, técnicas inmunocitoquímicas, uso de microscopios, etc.
Te recomendamos leer sobre los distintos Tipos de células en este otro artículo. Además, te puede interesar profundizar en los temas de la Célula animal: partes y funciones y Célula vegetal: partes y funciones con estos otros posts de BIOenciclopedia.
Aplicaciones de la biología celular y su importancia
Debido a que la biología celular se centra en las células y estas están presentes en todos los seres vivos, su área de estudio es muy amplia, haciendo que sus aplicaciones sean muy diversas. Se pueden encontrar aplicaciones de la biología celular en campos tan importantes como la medicina, la industria alimentaria y medio ambiente, la biotecnología y el control de plagas, entre otros. A continuación, aprenderemos algunos ejemplos de estas aplicaciones:
Medicina
Hoy en día se sabe que cuando una célula pierde la capacidad de evaluar el espacio en su entorno inmediato, sufre una alteración en su ciclo vital que la lleva a crecer y dividirse sin control, generando grandes masas celulares que se conocen como tumores. Estos tumores son los que dan lugar a la enfermedad del cáncer y gracias a las aportaciones de la biología celular se han podido desarrollar tratamientos de control y contención de alguna de estas células tumorales.
Industria alimentaria y medio ambiente
La obtención de variedades de plantas que puedan crecer en condiciones adversas, con menos agua o generar productos de mayor tamaño es un objetivo continuamente perseguido en la industria alimentaria. En base al conocimiento que aporta la biología celular, se han podido obtener variedades que reúnen estas características, dando lugar a cultivos más eficientes o menos costosos en muchos casos, algunos de los cuales pasan por el cultivo de transgénicos desarrollados gracias a la biología celular.
Biotecnología
El desarrollo de terapias personalizadas, vacunas para nuevas amenazas sanitarias y obtención de subproductos de interés está estrechamente relacionado con el conocimiento de las células implicadas en estos procesos y, por tanto, con la biología celular. A raíz del estudio de una bacteria patógena y del papel de nuestras células en el sistema inmune humano se pueden crear nuevas vacunas para combatir su infección. Por otra parte, el conocimiento en detalle de los microorganismos que llevan a cabo la fermentación láctica o alcohólica permite poner en marcha industrias encargadas de la obtención de bienes como las bebidas alcohólicas o los productos derivados de la leche.
Control de plagas
Tanto en el control de plagas bacterianas, como en el control de plagas de artrópodos (generalmente insectos), se utilizan organismos huéspedes cuyas células han desarrollado una defensa frente a estos patógenos, ya sea de forma natural o mediante manipulación. De esta forma se puede conseguir una reducción del uso de plaguicidas, además de una producción más responsable con el medio ambiente.
Como se puede extraer de todo esto, la biología celular tiene una gran relevancia para el ser humano. Gracias a ella se han conseguido desarrollar industrias enteras, así como técnicas para actualizarlas y mejorarlas frecuentemente.
Mediante su estudio, el ser humano es capaz de llevar a cabo cultivos cada vez más eficientes y especializados, dando la posibilidad de generar comida para la población mundial de forma más sostenible y limpia. Además, permite ahondar en el conocimiento del sistema inmune animal, lo que quizás sea una de las aportaciones de mayor peso abarcando a la medicina y la veterinaria, tan relevantes para el bienestar global. Tratamientos para el cáncer, enfermedades de transmisión sexual, trastornos genéticos, enfermedades degenerativas, enfermedades del sistema nervioso, trastornos alérgicos e intolerancias son solo algunos de los muchos ejemplos de aportaciones que la biología celular ha hecho, y continuará haciendo, al ámbito médico.

Grandes hitos de la biología celular
La biología celular no surge en un momento determinado de la historia, sino que se crea progresivamente a través del aporte de diferentes estudiosos hasta adquirir el carácter de ciencia. Es por esto que el primer hito, el nacimiento de la disciplina, no se suele ubicar en una fecha determinada y se asocia a la revolución científica de los siglos XVII y XVIII.
Generalmente, se considera a Anton van Leeuwenhoek, quien estudió rigurosamente por primera vez la célula utilizando microscopios simples, como uno de los principales precursores de esta disciplina junto con Robert Hooke, quien por separado fue uno de los primeros observadores de las células y el responsable de ponerles nombre. Asimismo, Marcello Malpighi fue uno de los encargados de popularizar el estudio de las células y establecer la idea de que los tejidos biológicos están compuestos por ellas.
Una vez atendido el nacimiento de la biología celular, se pueden destacar los siguientes sucesos:
- Publicación de los postulados de la Teoría Celular: en 1838 Matthias Schleiden y Theodor Schwann anuncian la que sería uno de los pilares de la biología y alrededor de la cual orbita la biología celular.
- Estudio y descripción de orgánulos: en la década de 1850 se lleva a cabo el descubrimiento y descripción detallada de muchos de los orgánulos de las células eucariotas que conocemos hoy en día, como son las mitocondrias, los cloroplastos y el núcleo.
- Teoría de la herencia y mutación: entre las décadas de 1880 y 1900 se da una importante proliferación del conocimiento sobre la genética de la célula, August Weissmann elabora la primera teoría de la herencia que habla de gametos, mientras que las mutaciones se sitúan en el foco de estudio de la biología celular gracias al redescubrimiento de los trabajos de Mendel por Hugo de Vries.
- Gran desarrollo de la biología molecular: como disciplina dentro de la biología celular, contribuyó durante las décadas de 1940 y 1950 a numerosos avances en el conocimiento de los componentes de la célula, siendo el más destacable el descubrimiento de la estructura del ADN por Watson y Crick.
- Teoría de la endosimbiosis: ya en 1970, la prolíficabióloga Lynn Margulis publica su teoría, que es ampliamente aceptada y determina que los orgánulos celulares se originaron por la internalización de células procariotas en células eucariotas, dando lugar a un fenómeno de endosimbiosis.
Ya en el siglo XXI, los principales descubrimientos se centran en la biología del desarrollo, lo que tiene aplicaciones en medicina relacionadas con extremidades con problemas de malformación, síntesis de tejidos, regeneración celular, trasplantes de órganos de animales a humanos y síntesis de órganos completos.
Diferencias entre biología celular y molecular
Cuando se habla de biología molecular, hay que hacer una aclaración importante. Dado que se trata de una subdisciplina de la biología celular, ambas están estrechamente relacionadas, pero también claramente diferenciadas en cuanto al sujeto de estudio.
Mientras que en la biología celular el objeto de estudio es la célula, así como sus funciones y relaciones, la biología molecular pone el foco en sus componentes tanto orgánicos como inorgánicos, pudiendo estudiarlos en su contexto, en el que forman parte del proceso orgánico de la vida, o bien de forma aislada con una perspectiva puramente físico-química y estructural.
Ahora que ya conoces qué es la biología celular y varios aspectos de ella, te aconsejamos leer estos otros artículos acerca de Qué es la Biología y Teoría celular: postulados, origen y evolución.
Si deseas leer más artículos parecidos a Biología celular: qué es, aplicaciones e importancia, te recomendamos que entres en nuestra categoría de Biociencia.
- Alberts, B. (2016). Biología Molecular de la Célula. 6ª edición, Ediciones Omega.
- Murray SM, McKay PF. (2021). Chlamydia trachomatis: Cell biology, immunology and vaccination. Vaccine.
- Albritton, C.C. (1980).Changing Conceptions of the Earth’s Antiquity after the Sixteenth Century.







